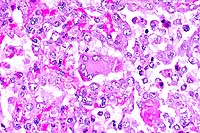

Results
AFIP Wednesday Slide Conference - No. 24
March 17, 1999
- Conference Moderator:
Dr. Corrie Brown, Diplomate, ACVP
Chairman, Department of Pathology
College of Veterinary Medicine
University of Georgia
Athens, Georgia 30602-7388
-
- NOTE: Click on images for larger views. Use
browser's "Back" button to return to this page.
Return to WSC Case Menu
-
Case I - E95481 (AFIP 2642606)
- Signalment: Seven-year-old, breed unspecified, male
horse.
-
- History: In the course of epidemic control of glanders
on a number of Turkish islands, 1,128 horses were examined using
the intracutaneous mallein test. Thirty-five horses (3.1%) showed
a positive reaction. Ten of these horses were killed, and glanders
was confirmed in five cases by lesions and demonstration of Burkholderia
mallei antigen.
-
- Gross Pathology: Bloody, purulent exudate was found
in the nasal cavity and paranasal sinuses. Beneath the exudate
there were yellowish-white, firm, nodules which measured up to
3 mm in diameter. Larger foci were found, which tended to become
confluent and ulcerated. The bases of the ulcers were granulated
and had irregular borders. Identical lesions were found in the
nostrils and upper lip.
-
- Laboratory Results: Burkholderia mallei antigen was
found in the mucous membrane of the nasal septum and the conchae
by immunohistochemistry.
-
- Contributor's Diagnosis and Comments: Acute inflammation
of nasal mucous membranes with marked thrombosis of large venous
vessels, infiltration of mucosa and submucosa with neutrophilic
granulocytes and macrophages, and ulcers.
Etiology: Burkholderia mallei (glanders).
-
- Clinical and pathological findings in the case presented
here, and in the other identified horses, indicated that lesions
were restricted to the mucous membranes of the nasal cavity,
its parasinuses, the nostrils, and the upper lips. The histological
findings were characterized by acute inflammation; the lack of
chronic features of inflammation, such as epithelioid cells,
lymphocytes, and fibrous connective tissue was striking. Karyorrhexis,
the previous "pathognostic" feature of a glanderous
lesion, was not present. The study, which combined mallein testing
with histopathology and immunohistochemistry, demonstrated the
presence of Burkholderia mallei in horses and proved that glanders
is endemic in certain parts of Turkey. There were no recent reports
of infections in humans.
-
- In experimental infections of the Syrian hamster with B.
mallei, the inflammatory reaction is similar, at least in the
nasal cavity (e.g. vasculitis). Concerning other organs, the
natural equine cases cannot be compared due to the lack of lesions
in corresponding organs in the horses. In the experimental case
cited, a thorough study of the glanders bacillus was done. The
study of the submitted case was limited to the identification
of bacterial antigen in the natural cases of equine glanders
by immunohistochemistry.
 4x
obj
4x
obj 10x
obj
10x
obj
- Case 24-1. Low power view has necrosis and inflammation
of nasal mucosa and thrombosis of nasal vessels. Larger thrombus
demonstrates lines of Zahn (layers of fibrin, wbcs, platelets,
RBCs, etc). Higher power view of vessel wall infiltrated and
replaced by mostly degenerate neutrophils and fibrin. Lines of
Zahn are seen more clearly on the left.
-
- AFIP Diagnosis: Nasal conchae: Rhinitis, necrotizing,
suppurative, diffuse, severe, with multiple thrombi and vasculitis,
breed unspecified, equine.
-
- Conference Note: Burkholderia mallei, the cause of
glanders and farcy, is a small, aerobic, nonsporulating, gram-negative
bacillus. It is an obligate parasite found principally in Asia,
North Africa, and Eastern Europe. The bacterium primarily infects
horses and donkeys, and the nasal sinuses, lungs, and skin of
the extremities are the usual sites of involvement. The respiratory
form of disease is commonly referred to as "glanders",
while cutaneous disease is commonly known as "farcy".
B. mallei is zoonotic, and humans become infected through contact
with the organism in the laboratory or via infected animals.
Infection in humans may cause acute, fatal pyemia or chronic
granulomatous disease. Dogs and cats have also been infected.
The disease was officially eradicated from the United States
in 1937.
-
- Infection in equidae usually occurs through ingestion or
aspiration of material contaminated with the bacteria. Infection
is spread by discharges of actively infected animals and subclinical
carriers, often around feed bunks and watering troughs. Contamination
of skin lesions and abrasions may also result in infection. After
ingestion, bacteria invade the intestinal wall and localize in
the lungs, skin, nasal mucosa, and other viscera. Humans and
carnivores may be infected through ingestion of the organism,
such as by consumption of contaminated horse meat, or by contact
of mucous membranes with exudates containing the bacteria.
-
- The severity of clinical signs and lesions in equidae is
dependent upon the species infected and the virulence of the
bacterial strain. Glanders is an acute, severe, systemic disease
in donkeys and mules. The high mortality rate is usually due
to bronchopneumonia. In horses, glanders is often chronic and
may be subclinical. In all forms of the disease, pathological
findings are characterized by poorly encapsulated pyogranulomas
which spread locally or disseminate along lymphatics. In the
nasal form, spreading nodular lesions occur which ulcerate the
mucosa and may perforate the septum. A unilateral or bilateral,
yellow, nasal discharge is frequently observed, and is highly
infectious. Healed nasal ulcers may appear as stellate-shaped
scars. In the cutaneous form, multiple, pyogranulomatous nodules
occur along lymphatics which become enlarged and filled with
purulent material, known as "farcy pipes"; rupture
of the nodules, which contain tenacious exudate and organisms,
frequently occurs. The pulmonary form is characterized by variable
numbers of pyogranulomatous lesions scattered throughout the
lung parenchyma; few pulmonary nodules are found in subclinical
carriers, while more extensive lung involvement occurs in fatal
cases. Regional lymph node involvement is common, and orchitis
may occur.
-
- Contributor: Institut of Veterinary Pathology, University
of Munich, Veterinarstr. 13, Munich, Germany 80539.
-
- References:
- 1. Arun S, et al.: Equine glanders in Turkey. Vet Rec 144:255-258,
1999.
- 2. Alibasoglu M, et al.: Malleus-Ausbruch bei lowen im zoologischen
garten Istanbul. Berl Munch Tierarztl Wschr 99:57-63, 1986.
- 3. Al-Izzi SA, et al.: In vitro susceptibility of Pseudomonas
mallei to antimicrobial agents. Comp Immun Microbiol Infect Dis
12:5-8, 1989.
- 4. Al-Kafawi AA, et al.: Haematological changes in Arabian
horses infected with glanders. Vet Rec 101:427, 1977.
- 5. Major Verma RA: Glanders in India with special reference
to incidence and epidemiology. Indian Vet Journal 58:177-183,
1981.
- 6. Zubaidy AJ, et al.: Pathology of glanders in Iraq. Vet
Pathol 15:566-568, 1978.
- 7. Jones TC, RD Hunt, King NW: Diseases caused by bacteria.
In: Veterinary Pathology, 6th edition, pp. 450-451, Williams
and Wilkins, Baltimore, MD, 1997.
- 8. Brown C: The respiratory system: Glanders. In: Equine
Medicine and Surgery, Colahan PT, et al., eds., 5th ed., pp.
536-538, Mosby, Inc., St. Louis, MO, 1999.
- 9. Logas DB, Barbet JL: Integument: Diseases characterized
by granulomatous draining nodules or masses. In: Equine Medicine
and Surgery, Colahan PT, et al., eds., 5th ed., page 1886, Mosby
Inc., St. Louis, MO, 1999.
-
Case II - 197072 (AFIP 2658217)
-
- Signalment: Four-month-old, male, Saanen kid, caprine.
History: The kid was submitted for postmortem examination
with a history of mild fever (40.8°C), mild dyspnea, and
cough. Several other kids in the herd were showing similar clinical
signs.
-
- Gross Pathology: On postmortem examination, multifocal
erosions were present on the oral mucosa of the hard and soft
palate. Small amounts of blood-stained contents were found in
the gastrointestinal tract, especially in the large intestine.
In the respiratory tract, multifocal hemorrhage and ulceration
of the laryngeal mucosa were present with flakes of mucopurulent
discharge. The lungs were partially consolidated, especially
the anteroventral lung lobes.
Laboratory Results: Peste des petits ruminants
was diagnosed by immunofluorescence, PCR, and AGPT.
-
- Contributor's Diagnosis and Comments: Lung: Bronchopneumonia,
subacute, diffuse, severe, with necrotizing bronchiolitis, type
II pneumocyte hyperplasia, syncytial cells, and intranuclear
and intracytoplasmic eosinophilic inclusions in airway epithelial
cells.
 40x
obj
40x
obj
- Case 24-2. Lung. Alveolar septa are thickened by hypertrophic
type II pneumocytes, and alveoli are often filled with cellular
debris and rare multinucleate giant syncytial cells bearing bright
pink intranuclear and intracytoplasmic inclusions.
-
- AFIP Diagnosis: Lung: Pneumonia, broncho-interstitial,
necrotizing, subacute, diffuse, severe, with type II pneumocyte
and bronchiolar epithelial hyperplasia, syncytial cells, and
eosinophilic intranuclear and intracytoplasmic inclusion bodies,
Saanen, caprine, etiology consistent with peste des petits ruminants
virus.
-
- Conference Note: Peste des petits ruminants (PPR),
a contagious viral disease of sheep and goats, is similar clinically
and pathologically to rinderpest in cattle and frequently manifests
as diarrhea, stomatitis, oculonasal discharge, and pneumonia.
The causative pathogen is a morbillivirus of the family Paramyxoviridae.
In natural infections, the virus causes disease in goats and
sheep, but not cattle or swine. Goats are considered to be more
susceptible than sheep, but this is not always true. Morbilliviruses
are important pathogens of humans and animals; in addition to
PPR, classic members of this genus cause rinderpest in cattle,
distemper in dogs, and measles in humans. Phocine and cetacean
morbilliviruses have been described recently.
-
- PPR is an economically important disease that was first reported
in the Ivory Coast of Africa in 1942, and has since spread east
to parts of Asia, including India and Pakistan. The African and
Asian strains seem to be antigenically distinct. There is current
concern that the virus may pose a serious threat to endangered
wild goats and sheep in the Himalayas through contact with infected
domestic sheep and goats. Transmission occurs by inhalation of
aerosols from closely associated animals, by direct contact through
licking and nuzzling, and occasionally through fomites such as
water troughs and feed bunks recently used by infected animals.
-
- Pathological changes associated with PPR include erosive
stomatitis and enterocolitis, similar to that of rinderpest in
cattle, and proliferative and necrotizing broncho-interstitial
pneumonia. Lymphoid depletion or necrosis occurs in the spleen,
Peyer's patches, and lymph nodes. In fatal cases, pneumonia may
not be as severe in younger goats (less than 4 months) than in
older animals (over 6-7 months), probably because young kids
succumb to dehydration caused by diarrhea before pulmonary lesions
can fully develop.
-
- PPR-induced pneumonia shares several histologic features
with the lung lesions of distemper in dogs and measles in humans.
Broncho-interstitial pneumonia occurs, and characteristic large,
multinucleate (syncytial) cells containing intracytoplasmic and
intranuclear inclusions are found within alveoli and terminal
bronchioles. Secondary bacterial infections are also common.
-
- Contributor: Ministry of Agriculture and Rural Development,
Veterinary Services, Kimron Veterinary Institute, PO Box 12,
Beit Dagan, Israel 50250.
-
- References:
- 1. Taylor WP, Busaidy A, Barrett T: The epidemiology of peste
des petits ruminant in Sultanate of Oman. Vet Microbiol 22:341-352,
1990.
- 2. Barker IK, Van Dreumel AA, Palmer N: The alimentary system.
In: Pathology of Domestic Animals, Jubb KVF, Kennedy PC, Palmer
N, eds., 4th ed., vol. 2, page 162, Academic Press, San Diego,
CA, 1993.
- 3. Kulkarni DD, et al.: Peste des petits ruminants in goats
in India. Vet Rec 138:187-188, 1996.
- 4. Amjad H, et al.: Peste des petits ruminants in goats in
Pakistan. Vet Rec 139:118-119, 1996.
- 5. Brown CC, Mariner JC, Olander HJ: An immunohistochemical
study of the pneumonia caused by peste des petits ruminants virus.
Vet Pathol 28:166-170, 1991.
- 6. Rossiter PB, Taylor WP: Peste des petits ruminants. In:
Infectious Diseases of Livestock, Coetzer JA, Thomson GR, Tustin
RC, eds., pp. 758-763, Oxford University Press, Cape Town, South
Africa, 1994.
- 7. Jones TC, RD Hunt, NW King: Diseases caused by viruses.
In: Veterinary Pathology, 6th edition, pp. 310-320, Williams
and Wilkins, Baltimore, MD, 1997.
Case III - M37 (AFIP 2648323)
- Signalment: 18-month-old, female, European, shorthair
cat.
-
- History: An outdoor, unvaccinated cat was presented
with a five day history of fever (40oC) and anorexia associated
with the onset of diffuse swelling of the right mammary gland.
The mammary glands were firm, painful, and focally ulcerated.
All four limbs were severely edematous. The health status declined
rapidly, and the animal was euthanatized. A necropsy was not
performed.
-
- Gross Pathology: See clinical description above.
-
- Laboratory Results: None.
-
- Contributor's Diagnoses and Comments:
- 1. Dermatitis, hyperplastic, ulcerative, chronic, with intracytoplasmic
eosinophilic inclusion bodies (feline poxvirus).
2. Mastitis and panniculitis, pyogranulomatous, necrotizing,
chronic-active, with intranuclear inclusion bodies.
-
- Lesions typical of epidermotropic poxvirus infection were
present, i.e. epidermal hyperplasia, ballooning degeneration
of keratinocytes, and presence of numerous, variably-sized, intracytoplasmic
eosinophilic bodies. Ultrastructurally, these inclusions were
made up of large (300-450 nm) mature virions within a protein-rich
material ("A-type inclusions"). Early viral particles
were scattered within the cytoplasm.
-
- The epidermal ulceration was associated with severe, deep,
pyogranulomatous, necrotizing panniculitis and mastitis. Within
this inflammatory process, nuclei of reactive histiocytes and
fibroblastic cells were enlarged and contained basophilic to
amphophilic intranuclear inclusion bodies. The inclusions occasionally
filled the nucleus, which was delineated by a thin rim of chromatin.
These nuclear changes suggest a viral infection such as herpesvirus.
Ultrastructural studies are on-going to determine their nature.
-
- The Poxviridae are highly epitheliotropic DNA viruses causing
cutaneous and systemic disease in birds, wild and domestic mammals,
and humans. Feline poxvirus infection, first reported in 1978,
is recognized with increasing frequency in Europe, usually in
the autumn. Cats are thought to become infected through bites
sustained during hunting of wild rodents, which are considered
to be the natural reservoir. Transmission of poxviruses from
rodents to man through the domestic cat may become of zoonotic
significance, particularly since the cessation of smallpox vaccination.
Cat-related human poxvirus infections have been reported, including
one with a fatal outcome in an immunosuppressed patient.
About 50% of infected cats develop a single, cutaneous, bite-like,
ulceration on the head, neck, forelimbs or paws. Secondary skin
lesions develop 4 to 16 days later and consist of multiple (more
than 10), firm, 2 to 3 mm nodules, enlarging over 2 to 3 days
to form up to 2 cm ulcerated papules. Oral mucosal ulcerations
and systemic signs are uncommon. Most cats recover in 1 to 2
months; however, death has been reported in cats with evidence
of feline leukemia virus infection and in cats treated with glucocorticoids.
In this case, the cat developed systemic signs leading to euthanasia.
Although no laboratory work-up was done (such as FeLV and FIV
testing), the rapid health deterioration and the probable dual
viral infection suggest an immunodeficient status.
 2x
obj
2x
obj 40x
obj
40x
obj
- Case 24-3. Haired skin. The dermis and subcutis beneath
a thickened epidermis is expanded by edema and infiltrating inflammatory
cells which surround and separate normal dermal elements. High
power of the epidermis illustrates multiple brightly eosinophilic
intracytoplasmic inclusions within keratinocytes, multifocal
neutrophilci infiltrates, and parakeratotic hyperkeratosis.


- Case 24-3. Several intracytoplasmic inclusions within
a degenerating cell contain multiple electron dense dumbell shaped
virions characteristic of poxvirus.
-
- AFIP Diagnosis: Haired skin: Dermatitis, proliferative
and necrotizing, diffuse, moderate, with neutrophilic, histiocytic,
hemorrhagic, and fibrinous panniculitis, necrotizing vasculitis,
and eosinophilic intracytoplasmic epithelial, fibroblastic, and
histiocytic inclusions, Domestic Shorthair, feline.
-
- Conference Note: Conference participants generally
agreed with the histopathologic findings described by the contributor.
However, attendees did not identify intranuclear viral inclusions
within histiocytes and fibroblasts. Rather, participants interpreted
the nuclear structures as prominent nucleoli or clumped chromatin
associated with degenerative or reactive changes. Viral particles
were not identified within nuclei in ultrastructural studies
performed by the contributor subsequent to the submission of
the case to the Wednesday Slide Conference; the contributor subsequently
interpreted the nuclear changes as degenerative.
-
- Contributor: Laboratoires Pfizer, BP 159, 37401 -
Amboise Cédex, France.
-
- References:
- 1. Bennett M, et al.: Poxvirus infection in the domestic
cat: Some clinical and epidemiological observations. Vet Record
118:387-390, 1986.
- 2. Eis-Hübinger AM, et al.: Fatal cowpox-like virus
infection transmitted by cat. Lancet 336:880, 1990.
- 3. Gaskell RM, et al.: Natural and experimental pox virus
infection in the domestic cat. Vet Record 112:164-170, 1983.
- 4. Nowotny N: The domestic cat: A possible transmitter of
viruses from rodents to man. Lancet 343:921, 1994.
- 5. Thomsett LR, Baxby D, Denham EMH: Cowpox in the domestic
cat. Vet Record 103:567, 1978.
- 6. Stolz W: Characteristic but unfamiliar the cowpox infection,
transmitted by a domestic cat. Dermatology 193:140-143, 1996.
- 7. Yager J, Scott D: The skin and appendages. In: Pathology
of Domestic Animals, Jubb KVF, Kennedy PC, Palmer N, eds., 4th
ed., vol. 1, pp. 633-635, Academic Press, San Diego, CA, 1993.
- 8. Nowotny N: [Serologic studies of domestic cats for potential
human pathogenic virus infections from wild rodents]. Zentralb
Hyg Umweltmed 198:452-461, 1996.
- 9. Czerny CP, et al.: Characterization of a cowpox-like orthopoxvirus
which had caused a lethal infection in man. Arch Virol Suppl
13:13-24, 1997.
-
Case IV - TAMU 1998 2 (AFIP 2641894)
- Signalment: Yearling, male white-tailed deer (Odocoileus
virginianus).
-
- History: The deer was admitted with a 7-10 day history
of lethargy and anorexia. No diagnosis was made; however, the
deer broke with a watery diarrhea. Pieces of what were interpreted
to be sloughed mucosa were passed in the feces. The animal was
not febrile and was euthanized in extremis.
-
- Gross Pathology: Ascites (200 ml of clear fluid) and
intestinal serosal petechiae were noted. There was a fibrinous
cast in the terminal half of the small intestines, the cecum,
rectum and spiral colon.
-
- Laboratory Results:
1. WBC: 1100
2. Total protein: 3.5 g/dl
- Tests for bovine viral diarrhea virus, Salmonella sp., and
Clostridium sp. (specifically for Clostridium difficile and its
toxin) were negative. PCR of the spleen for malignant catarrhal
fever (MCF) was positive.
-
- Contributor's Diagnosis and Comments: Acute necrotizing
enterocolitis.
Etiology: Malignant Catarrhal Fever (MCF).
-
- This deer was raised in captivity on a sheep farm, an epidemiologic
feature of histories of US cattle affected with MCF. In addition
to laboratory tests, further support for the MCF diagnosis was
provided by histology. There was vasculitis of several organs
and lymphoblastic infiltration of the choroid plexus (without
encephalitis and vasculitis of the brain; see figure 4 of Wobeser
reference). The hemogram also suggested a viral infection.
-
- The etiologic agent for endemic MCF of the US has not been
isolated, and it is presumed to be a herpesvirus. Herpesvirus
particles have been seen in tissues from naturally occurring
disease. In the US, cattle affected with MCF typically have anterior
uveitis, a mucopurulent oculonasal discharge, muzzle and oral
erosions, and a high fever. Diarrhea is also described with this
disease. "Milky eye" (anterior uveitis) and a progressive
CNS syndrome with fever and a variety of lesions and signs are
described in MCF affected deer on exotic game ranches in Texas,
but there is variability to the syndrome seen (see references).
-
- This deer's clinical disease is similar to that described
for white-tailed deer. The enterocolitis is typical of that seen
with severe viral enteritis, and using one's imagination, there
are numerous "herpesvirus-like" inclusions in enterocytes.
Lesions of MCF in Asian deer species are different and sometimes
suggest that the agent of MCF may be oncogenic.
 10x
obj
10x
obj 40x
obj
40x
obj
- Case 24-4. Small intestine. Thickened, blunted villi
are expanded by abundant lymphocytes, macrophages, and fewer
eosinophils. The hypertrophic, vacuolated endothelium of a small
arteriole is infiltrated by lymphocytes and neutrophils.
-
- AFIP Diagnosis: Small intestine and colon: Enterocolitis,
subacute, diffuse, severe, with follicular lymphoid depletion,
transmural edema, crypt abscesses, and crypt necrosis, loss,
and regeneration, white-tailed deer (Odocoileus virginianus),
cervid.
-
- Conference Note: Malignant catarrhal fever (MCF) is
a systemic, frequently fatal, viral disease of cattle and various
other ruminants. Two forms of the disease occur which are clinicopathologically
similar, but epidemiologically distinct. One form occurs in susceptible
animals that commingle with wildebeest (a member of the subfamily
Alcephaline), and is known as wildebeest derived-MCF; the causative
agent is alcelaphine herpesvirus-1 and is foreign to the United
States. The second form, endemic in the US, occurs in animals
in contact with sheep. Sheep-associated MCF is caused by ovine
herpesvirus-2 (OHV-2), a g-herpesvirus. It shares genetic and
biological characteristics with alcelaphine herpesvirus-1 and
herpesvirus saimiri.10
- White-tailed deer are experimentally susceptible to both
forms of MCF, and several natural infections have been reported.
Compared to cattle, the disease in deer is more acute, infected
animals may have fewer clinical signs prior to death, the lesions
are more hemorrhagic, and there is increased visceral involvement.
In deer, gastrointestinal and myocardial lesions are prominent;
these are seen less frequently in cattle succumbing to MCF.
-
- Several findings described by the contributor are consistent
with previous reports of sheep-associated MCF in deer: a history
of close association with sheep; clinical signs of lethargy,
anorexia, and watery diarrhea; lymphoblastic infiltration of
the choroid plexus; and the results of the laboratory tests.
Like the contributor, all participants identified severe necrotizing
enterocolitis. In some sections, there is mild necrotizing vasculitis
affecting some medium-sized arterioles in the submucosa and serosa.
However, participants did not identify fibrinoid degeneration
of vessels, prominent perivascular inflammatory infiltrates,
or proliferation of lymphoblastic cells in the mucosa or submucosa;
these histologic features have been used to distinguish sheep-associated
MCF from other infectious agents with similar clinicopathological
presentations, especially other viral etiologies. Conference
participants considered bluetongue, epizootic hemorrhagic disease,
bovine viral diarrhea, and colibacillosis in the differential
diagnosis for the intestinal lesions.
-
- Contributor: Texas A&M University, Department
of Veterinary Pathobiology, College of Veterinary Medicine, College
Station, TX 77843-4467.
-
- References:
- 1. Blake JE, Nielson NO, Heuschele WP: Lymphoproliferation
in captive wild ruminants affected with malignant catarrhal fever:
25 cases (1977-1985). J Amer Vet Med Assoc 196:1141-1143, 1990.
- 2. Clark K, Adams LG: Viral particles associated with malignant
catarrhal fever in deer. Amer J Vet Res 37:837-840, 1976.
- 3. Clark K, Robinson RM, Marburger RG, Jones LP, Orchard
JM: Malignant catarrhal fever in Texas cervids. J Wildl Dis 6:376-383,
1970.
- 4. Clark K, Robinson RM, Weishuhn LL: Further observations
on malignant catarrhal fever in Texas deer. J Wildl Dis 8:72-74,
1972.
- 5. Liggitt HD, DeMartini JC: The pathomorphology of malignant
catarrhal fever. I. Generalized lymphoid vasculitis. Vet Pathol
17:58-72, 1980.
- 6. Liggitt HD, DeMartini JC: The pathomorphology of malignant
catarrhal fever. II. Multisystemic epithelial lesions. Vet Pathol
17:73-83, 1980.
- 7. Liggitt HD, DeMartini JC, McChesney AE, Pierson RE, Storz
J: Experimental transmission of malignant catarrhal fever in
cattle: Gross and histopathologic changes. Amer J Vet Res 39:1249-1257,
1978.
- 8. Wobeser G, Majka JA, Mills JHL: A disease resembling malignant
catarrhal fever in captive white-tailed deer in Saskatchewan.
Can Vet Journal 14:106-109, 1973.
- 9. Brown CC, Bloss LL: An epizootic of malignant catarrhal
fever in a large captive herd of white-tailed deer (Odocoileus
virginianus). J Wildl Dis 28:301-305, 1992.
- 10. Schock A, Collins RA, Reid HW: Phenotype, growth regulation
and cytokine transcription in ovine herpesvirus-2 (OHV-2)-infected
bovine T-cell lines. Vet Immunol Immunopathol 66:67-81, 1998.
-
- Course Coordinator:
- Ed Stevens, DVM
Captain, United States Army
Registry of Veterinary Pathology*
Department of Veterinary Pathology
Armed Forces Institute of Pathology
(202)782-2615; DSN: 662-2615
Internet: STEVENSE@afip.osd.mil
-
- * The American Veterinary Medical Association and the American
College of Veterinary Pathologists are co-sponsors of the Registry
of Veterinary Pathology. The C.L. Davis Foundation also provides
substantial support for the Registry.
-
- Return to WSC Case Menu
 4x
obj
4x
obj 10x
obj
10x
obj
 4x
obj
4x
obj 10x
obj
10x
obj
40x
obj
40x
obj
 2x
obj
2x
obj 40x
obj
40x
obj


 10x
obj
10x
obj 40x
obj
40x
obj